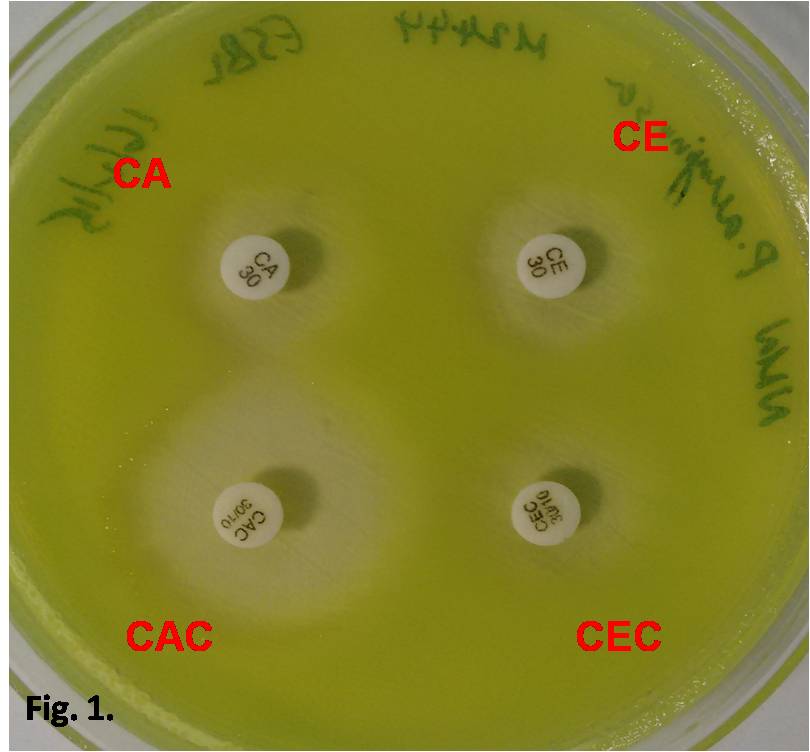
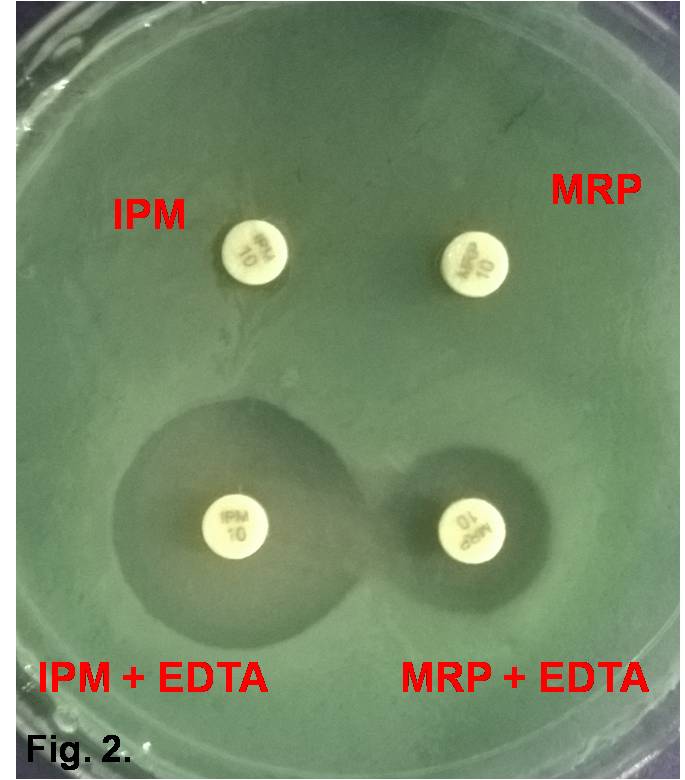

1Dept of Microbiology, L & T Microbiology Research Centre, Vision Research Foundation, Sankara Nethralaya, Chennai, Tamil Nadu, India 600006, 2Scholar, School of Chemical & Biotechnology, SASTRA University, Thanjavur, Tamil Nadu, India 613401
Email: drjm@snmail.org
Received: 11 Feb 2015 Revised and Accepted: 05 Mar 2015
ABSTRACT
Objectives: To evaluate the changing trends in antimicrobial susceptibility rate and detection of ESBL and MBL among Pseudomonas aeruginosa isolated from various ocular infections over a 2 year periods with special reference to detection of ESBL and MBL co-existence among P aeruginosa recovered from ocular infections.
Methods: All ocular specimens, culture positive for P aeruginosa (n=110) isolated from clinically suspected patients were submitted to L &T Microbiology Research Centre, Chennai, Tamil Nadu, India. Culture, antimicrobial susceptibility testing and ESBL detection was performed by Standard methods. MBL production was screened by Carbapenem-EDTA combination disk method.
Results: Of the 3247 samples subjected to culture from August 2012– July 2014 by standard method 276 were positive for bacterial growth, thereby 8.5% of ocular infections mediated by bacterial pathogens. Out of 276 culture positives 110 (39.8%) Pseudomonas aeruginosa isolates recovered from ocular infections. The resistance rate for commonly used drugs against ocular infection includes Gentamycin [23.63%], Gatifloxacin [20.9%], Moxifloxacin [20%], Tobramycin [20%], ciprofloxacin [19.09%]. Totally 15 (13.63%) out of 110 isolates were identified as ESBL producer and 11 (10%) out of 110 isolates were identified as MBL producer by screening test, including 7 isolates have co-produced both ESBL and MBL enzymes and 4 isolates were only positive for MBL production.
Conclusion: Though fluoroquinolones remains a good choice for ocular Pseudomonal infection. Gradual emergence of resistance to fluoroquinolones and aminoglycosides also noted from this study. The emergence of ESBL, MBL and pandrug resistance among P aeruginosa from ocular infections is an alarm rational finding which necessitates the earlier detection of both ESBL and MBL production as individual or co-existence in ocular isolates, which may pave the way for appropriate therapy for sight threatening conditions like endophthalmitis.
Keywords: Antimicrobial resistance, Pseudomonas aeruginosa, Keratitis, Ocular infections.
INTRODUCTION
Pseudomonas aeruginosa (P. aeruginosa) is a motile gram-negative rod that belongs to the family Pseudomonadaceae. P. aeruginosa, an ubiquitous organism frequently isolated from clinical specimens and accounts for a significant proportion of nosocomial infections [1]. A general problem with nosocomial infections is the tendency of the causative pathogen to acquire antibiotic resistance, whilst patient was under treatment [2]. P aeruginosa is known for its ability to resist killing by a variety of antibiotics. The minimal nutritional requirements of Pseudomonas, as evidenced by its ability to grow in distilled water and its tolerance to a wide variety of physical conditions, contribute to its ecologic success and ultimately in its role as an effective opportunistic pathogen [3]. P aeruginosa mediated ocular infection is frequently associated with contact lens wearer, since the exposure of bacterium to an ocular surface can easily occur through contaminated contact lens cases [4].
Emergence of P. aeruginosa as a major infective cause of corneal ulceration termed keratitis and, accounting for 8-21% of bacterial keratitis in South India [5]. Multidrug resistant (MDR) P aeruginosa keratitis is an increasing clinical problem wherein the treatment for patient becomes complicated, leading to blindness. The infection is an avoidable blindness recognized as a public health threat.
The mechanism of antibiotic resistance may be intrinsic (the microorganism is by definition resistant against a certain antibiotic) or acquired. Production of beta-lactamases is considered of major importance among resistant mechanisms, because these enzymes are frequently transferable and inactivate beta lactam antibiotics for a broad range. Out of this large enzymatic family, carbapenemases (class B) metallobetalactamases (MBLs) that contain zinc in their active site and class A KPC hydrolyze in vitro all or almost all beta-lactams, including carbapenems. The Class A extended spectrum beta-lactamases (ESBLs) hydrolyze penicillins, monobactams and cephalosporins whereas they are inhibited by the available beta-lactamase inhibitors [6].
Since, phenotypic method is an inexpensive, simple technique with fair reproducible result with easy interpretation method and can be used in any basic laboratories. The rational of this study is to detect and evaluate the ability of P aeruginosa recovered from ocular isolate(s) for the production of ESBL and MBL enzyme neither single nor coproduction of both enzymes using phenotypic methods. In literatures, scanty reports on ESBL and MBL producers among ocular isolates of P aeruginosa have been reported. In this context, the current study is a need for accurate and up to date information on the frequency and mode of resistance, resistance trends and comprehensive comparison of various antimicrobial agents tested against Pseudomonas aeruginosa in ocular infections.
Thus the information on the emergence of resistance with different antibiotics can be of practical use in guiding empiric therapeutic choices. In this study, we report the results of antibiotic susceptibility and multiple antibiotic resistance index of P aeruginosa isolates obtained from ocular specimens submitted to L & T Microbiology Research centre, Sankara Nethralaya, Chennai, Tamil Nadu, and India. The proposed study method can be used routinely to test antimicrobial sensitivity for accurate identification of resistant mechanism to guide the clinician for with appropriate drug regimen decision in the chemotherapy of P aeruginosa infections.
MATERIALS AND METHODS
A prospective analysis was done with 110 Pseudomonas aeruginosa isolated from patients with clinical diagnosis of bacterial ocular diseases, namely conjunctivitis, canaliculitis, keratitis, dacryocystitis, endophthalmitis, and panophthalmitis during the 2-year periods (July 2012–December 2014) from a total of 3247 specimens received for microbial culture at L & T Microbiology Research Centre, Kamalnayan Bajaj Research Centre, Sankara Nethralaya, a tertiary eye care center at Chennai, India. Study protocol was approved by the institutional ethics sub-committee (IRB). After the ocular examinations, using standard microbiological techniques, specimens for culture and smear were obtained (7, 8).
(ii) Identification of Pseudomonas aeruginosa isolates
The different ocular specimens submitted to L & T Microbiology Research Centre were cultured on blood agar, MacConkey agar and Brain Heart Infusion Broth (BHIB) and they were incubated at 37 °C for 24 hours and on Mueller Hinton agar plates to assess pigment production. The culture plates were processed using standard microbiological procedures, Characterization and identification of P. aeruginosa was carried out using a combination of colonial morphology, Gram stain characteristics, motility tests, pigmentation, oxidation-fermentation tests, catalase and oxidizer activity tests and pyocyanin production [9]. Detailed distribution of Pseudomonas aeruginosa among the ocular specimens was shown in table 1.
Phenotypic detection method
We used Standardard method of drug susceptibility testing using Muller-Hinton agar and bacterial isolates to be tested (in 0.5 McFarland's standard concentration), quality control strains Escherichia coli ATCC 35218 (positive control-ESBL) Klebsiella pneumoniae 700603 (MBL-Positive control) and Escherichia coli ATCC 25922 (negative control). One isolate was studied from each patient. The drug susceptibility pattern screened for Pseudomonas aeruginosa strains to Penicillins: ampicillin (10µg), amoxycillin (20µg), piperacillin (100µg); cephalosporins: cephalexin (30 µg), cefuroxime (30µg), cefazolin (30µg), cefotaxime (30µg), ceftriaxone (30µg), ceftazidime (30µg), cefoperazone (75 µg), cefpodoxime 10 µg), cefdinir (5 µg), cefepime (30 µg); Carbepenems: imipenem (10µg), meropenem (10 µg); monobactums: aztreonem (30 µg); combinations: ampicillin+sulbactum (10/10 µg), amoxycillin+clavulinic acid (20/10 µg), piperacillin+tazobactum (100/10 µg); Aminoglycosides: gentamicin (10 µg), tobramycin (10 µg), amikacin (30 µg); quinolones: ciprofloxacin (5µg), ofloxacin (5µg), levofloxacin (5µg), gatifloxacin (5µg); tetracyclines: doxycycline (30µg); macrolides: azithromycin (15µg) and miscellaneous: chloramphenicol (30 µg) respectively was investigated by the Kirby-Bauer disc diffusion method according to CLSI guidelines [10].
Mueller-Hinton broth was used as the growth medium. The final bacterial inoculum concentration was adjusted to 1.5x108 colony-forming units/ml (cfu/ml) followed by plates were inoculated with swabs submerged in the final inoculum concentration and swabbed over the entire surface of the media. The relevant antibiotic discs were placed over and incubated aerobically at 35-370C for 18-24 hours. All antibiotic discs were obtained from Hi-media. Pseudomonas aeruginosa ATCC 27853 was used as control for identification and susceptibility tests.
ESBL detection
ESBL test was performed by placing disks of ceftazidime (30 µg), cefotaxime(30 µg), ceftazidime-clavulanic acid(30/10 µg), and cefotaxime-clavulanic acid (30/10 µg), on Muller-Hinton agar (MHA) plates at a distance of 30 mm (center to center) from each other. ESBL production was inferred if the zones produced by the disks with clavulanate (an ESBL inhibitor) were ≥5 mm larger than those without inhibitor [11,12].
MBL detection
Phenotypic detection of MBL production (EDTA-IMP) was carried out for imipenem-resistant strains by dissolving 186.1 grams of disodium EDTA. 2H2O in 1000 ml of distilled water, 0.5 M EDTA solution was prepared and adjusted to pH 8 by adding sodium hydroxide. Then, 750 μg /disc was prepared by adding 5 microlitres of 0.5M EDTA solution per disc and was dried in the incubator. EDTA-imipenem (IMP) disk plus imipenem disk were placed in a MHA plate containing lawn culture of P. aeruginosa. After 18 h of incubation at 37 °C an organism was considered MBL positive if the inhibition zone diameter increased by ≥7 mm towards the IMP plus EDTA or Meropenem(MER) plus EDTA in comparison to IMP or MER disk alone [11, 12].
RESULTS
The present investigation was carried out to isolate and identify Pseudomonas aeruginosa from ocular specimens. All the Pseudomonas aeruginosa isolates were identified and confirmed based on various characteristics: colony morphology, bluish green pigmentation, non lactose fermenting colonies in macconckey agar, presence of motility, positive reaction for oxidase, catalase, simmon's citrate medium, nitrate reduction and mannitol sugar test and negative reaction for urease, indole, Methyl Red, Vogues Prosker test, sucrose, lactose and maltose sugar tests.
Of the 3247 samples subjected to culture from August 2012– July 2014 by standard method 276 were positive for bacterial growth, thereby suggesting 8.5% of ocular infections mediated by bacterial pathogens. Out of 276 culture positives, 110 (39.8%) isolates were found to be Pseudomonas aeruginosa. Among, 110 P aeruginosa isolates, 101 (91.8%) specimens were only positive for P aeruginosa growth and 8 (7.27%) isolates were identified with groups of bacterial strains other than P aeruginosa and 1 isolate (0.90%) was found to presence of fungal growth. The polymicrobial distribution of these 8 isolates were predominantly isolated from 7 (5.45%) corneal scraping composed of Staphylococcus epidermidis (3), Klebsiella pneumonia (2) and Aspergillus flavus(1) and 2 (1.81%) isolates were identified from eviscerated material with Staphylococcus epidermidis (2).
Of the 110 clinical isolates, the maximum number was isolated from 34 (37.4%) corneal scraping followed by 19 (20.9%) conjunctival swab (significant number of colonies found in any one culture media and BHIB were considered to be positive growth), 11(12.1%) vitreous aspirate and eviscerated material, 10(11%) corneal button, 7 (7.7%) Donor corneal Rim (DCR), 6 (6.6%) contact lens and each 1 (0.91%) from scleral scraping, corneal pus, infective suture, iris tissue, bandage from contact lens, conjuctival scraping and intraocular lens.
Out of 110 P aeruginosa tested, drug susceptibility rate was higher for beta lactam group of drugs such as 109 (99.09%) Aztreonam, 104 (94.5%) Cefepime, 100 (90.90%) for both Meropenem and cefdinir, 99(90%) Imipenem drug and the least susceptibility rate for 70 (63.63%) piperacillin followed by 76 (69.09%) amoxycillin and 80 (72.72%) cephalexin. Aminoglycosides suscebtibility was 96 (87.27%) amikacin followed by 83 (74.54%) tobramycin and 76 (69.09%) gentamycin. Quinolones/Fluoroquinolone susceptibility was 86 (78.18%) for both ciprofloxacin and gatifloxacin followed by 83(75.45%) moxifloxacin and 82(74.54%) for both norfloxacin and ofloxacin (Graph: 1)
Results for ESBL & MBL test
In ESBL confirmatory-cephalosporin/clavulanate combination disc test, Totally 15 (13.63%) out of 110 isolates displayed positive results against cefotaxime with clavulanic acid compared to cefotaxime alone and ceftazidime with clavulanic acid compared to ceftazidime alone. Among, 15 isolates 5 (5.5%) belonged to corneal button and 4 (4.4%) from corneal scraping isolates, 3 (3.3%) donor corneal rim and three each from Eviscerated material, vitreous aspirate, conjuctival swab respectively. MBL screening test using carbapenem-EDTA combination test showed 11 (10%) out of 110 positive results against Imipenem with EDTA compared to Imipenem alone and/or meropenem with EDTA as compared to meropenem alone. Out of 11 MBL positive isolates, corneal button 3 (2.72%), corneal scraping 4 (4.4%), donor corneal rim 2 (1.81%) and eviscerated material2 (1.81%). The co-existence of both ESBL and MBL were identified in 7 (6.36%) out of 110 isolates consist of corneal scraping 3(2.72%), corneal button 2 (1.81%) and each 1 (0.91%) from donor corneal rim and eviscerated material (table 1, Graph 2).
Fig. 1: ESBL confirmatory test-Double disk diffusion method. The inhibition zone around the CAC disk is apparently larger than around the CA disk, indicating ESBL production. But no comparable result is obtained with CEC disk and CE disk. Abbreviations: CA, Ceftazidime (30 µg); CAC, Ceftazidime+clavulanic acid (30/10 µg); CE, Cefotaxime (30 µg);CEC, Cefotaxime+Clavulanic acid (30/10 µg)
Fig. 2: Carbapenenem-EDTA Combination disk method for MBL detection. The inhibition zone around the IPM+EDTA and MRP+EDTA disk is apparently larger than around the IPM and MRP disk respectively, indicating MBL production. Abbreviations: IPM, Imipenem (10 µg); IPM+EDTA, Imipenem (10 µg)+5 µl 0.5M EDTA; MRP, Meropenem (10 µg); MRP+EDTA, Meropenem (10 µg)+5 µl 0.5M EDTA

Graph 1: Antimicrobial susceptibility pattern of Pseudomonas aeruginosa isolated from ocular infections

Graph 2: Specimen wise distribution of P aeruginosa and its betalactamases-ESBL and MBL mechanism detected by phenotypic method
Table 1: Shows distribution of ESBL and MBL results among ocular specimens identified by phenotypic methods
| S. No. | Specimen | Total No of Isolates | ESBL positive | ESBL+MBL positive | ESBL negative MBL positive | Total No of MBL |
| 1 | Donor Corneal Rim | 7 (6.36%) | 3 | 1 | 1 | 2 |
| 2 | Aqueous chamber Tap | 4(3.63%) | 0 | 0 | 0 | 0 |
| 3 | Corneal scraping | 34 (30.9%) | 4 | 3 | 1 | 4 |
| 4 | Conjuctival swab Donor Eye | 1 (0.9%) | 0 | 0 | 0 | 0 |
| 5 | Contact lens | 6 (5.45%) | 0 | 0 | 0 | 0 |
| 6 | Corneal button | 10 (9.09%) | 5 | 2 | 1 | 3 |
| 7 | Eviscerated material | 11(10.0%) | 1 | 1 | 1 | 2 |
| 8 | Vitreous aspirate | 11 (10.0%) | 1 | 0 | 0 | 0 |
| 9 | Conjuctival swab | 19 (17.27%) | 1 | 0 | 0 | 0 |
| 10 | Scleral scraping | 1 (0.9%) | 0 | 0 | 0 | 0 |
| 11 | Canalicular pus | 1 (0.9%) | 0 | 0 | 0 | 0 |
| 12 | Infective suture | 1 (0.9%) | 0 | 0 | 0 | 0 |
| 13 | Iris tissue | 1 (0.9%) | 0 | 0 | 0 | 0 |
| 14 | Bandage lens | 1 (0.9%) | 0 | 0 | 0 | 0 |
| 15 | Conjuctival scraping | 1 (0.9%) | 0 | 0 | 0 | 0 |
| 16 | Intra ocular lens | 1 (0.9%) | 0 | 0 | 0 | 0 |
| Total | 110(100%) | 15 (13.6%) | 7(6.36%) | 4(3.63%) | 11(10.0%) |
DISCUSSION
Keratitis and other ocular infections mediated by Pseudomonas aeruginosa is a significant cause of ocular morbidity and permanent blindness. Henceforth, it should be considered as an emergency and requires careful and urgent attention to initiate appropriate therapy [13]. The present study was initiated, due to increased rate of MDR P. aeruginosa encountered in ocular specimens. Currently, ESBL and MBL production were not screened routinely in microbiology labs due to cost and other factors. Despite, genetic analysis were standard for MBL production, due to equipments required for PCR analysis which is not affordable to all basic microbiological labs. Hence, we carried out the carbapenem-EDTA combination disk method for identification of MBLs among P aeruginosa recovered from ocular isolates.
In the current study P. aeruginosa was predominantly isolated from corneal ulcer 34 (30.9%). Trauma or infection was found to be the major risk factor for the development of P aeruginosa keratitis followed by pre-operative conjuctival swab 19 (17.27%). Contact lens (6 (5.45%)) wearer does not emerge as an important risk factor, though it is noted as a predominant cause for Pseudomonas keratitis in developed countries [4]. This difference could be attributed to the difference in type of contact lens being used among developed and developing countries as well as this study included mostly urban population hence their care of Contact lens usage and environmental factor plays major role [14].
The emergence of antibiotic resistant bacteria increases the patients stay at hospital, thus leading to an increased economic burden on them. In the present study, the antibiogram of the 110 isolates of P. aeruginosa showed resistance against piperacillin [36.36%], amoxycillin [29.09%], ampicillin and cephalexin [27.27%], cephozoline [26.36%] though amoxycillin, ampicillin were not used in ocular treatment, we screened those drugs in order to evaluate susceptibility pattern of P aeruginosa from ocular infection with other infections. Among the drugs commonly used for treating ocular infections, increased resistance was noted against Gentamycin [23.63%], Gatifloxacin [20.9%], Moxifloxacin [20%], Tobramycin [20%], ciprofloxacin [19.09%]. Our findings were similar to the observations by Ibukun et al., who reported a higher susceptibility [15]. Our findings differed from those of Diwivedi et al., Arya M et al. who reported a higher resistant rate among isolates obtained from post operative wound infections [16, 17]. Result of this study, shows that P aeruginosa from ocular isolates were more susceptible to newer fluoroquinolones, amikacin, Ciprofloxacin, Gatifloxacin and Moxifloxacin. However resistance rates is gradually emerging among P aeruginosa against gentamicin and moxifloxacin. These findings may show less similar to other researchers (Haleem et al., 2011, Ferguson et al., (2007) compared with our results [18-19], which is due to the isolate of our study included only ocular specimens, whereas most of the study includes wide group of specimens such as blood, urine, pus and etc., Studies with ocular isolates by (MJ Bharathi et al., 2002 and 2011) results were concordance with our findings [8,20].
Our study showed that among 110 Pseudomonas aeruginosa isolates, 15 [13.63%] were ESBL producers, which was nearly similar to 20.27 % and 22.22% ESBL producing isolates of P. aeruginosa reported by Aggarwal et al., Peshattiwar PD et al. [12,21]. The ESBL mediated resistance of P. aeruginosa to the third generation cephalosporins was non concordance with report of Uma et al. [77.3%], was much higher than that reported in the present study [22]. The interesting finding in our study is the identification of 7 ocular isolates for coproduction of both ESBL and MBL enzymes which is not observed by Peshattiwar PD et al. and Renata Picao et al. [12, 23].
We observed that only 9.09 % strains were resistant to carbapenem. In the present study, imipenem and meropenem showed good antipsuedomonal activity. A similar observation was made by Jaykumar S and Peshattiwar PD et al. 12,24], while a higher degree of carbapenem resistance was noted by Varaiya et al. [25%] [25]. This difference could be attributable to the study environment and nature of ocular specimens.
The most concerning development in recent years has been the emergence of carbapenemases among MDR P. aeruginosa. It is alarming to the scientific community that resistance to imipenem 9(8.18%) and meropenem 10(9.09%) resistance is observed among ocular P aeruginosa. Out of 110 P aeruginosa isolated, 11 [10%] isolates were found to be metallo β lactamases producers. The prevalence of MBLs in the present study was consistent with findings of Ibukun et al., Navaneeth et al., Peshattiwar PD et al., and others [12,15,26]. In the present study, 5 isolates [45.45 % out of 11] MBLs were resistant to all the antibiotics tested except aztreonam and one strain from eviscerated material showed resistance to all drugs including aztreonam. The presence of MBLs in the pandrug resistant isolates was already observed by Jaykumar S [24]. But emerging scenario of P aeruginosa with pandrug resistant strain(s) among ocular infections is an alert for scientific community which may leads to blindness.
In conclusion, the emergence of ESBL and MBL among P aeruginosa strains is noted in ocular setup. Earlier detection of co-existence of ESBL and MBL production by MDR P aeruginosa may pave the way for appropriate therapy. Further, our study underlines the unique problem of ESBL and MBL mediated resistance, which has created a therapeutic challenge for the clinicians and microbiologists. To overcome the problem of emergence and the spread of multidrug resistant P. aeruginosa, a combined interaction and cooperation between the microbiologists, clinicians and the infection control team is needed. So, efforts should be aimed at detecting such resistant bacteria along with their resistance mechanisms, controlling infections caused by them, and finally, providing better alternative therapies against these recalcitrant organisms.
ACKNOWLEDGEMENT
We thank the Indian council of medical research (ICMR), the funding agency, for their generous funding and support for the research work (project code AMR/10/2011-ECD-I).
CONFLICT OF INTERESTS
Declared None
REFERENCE